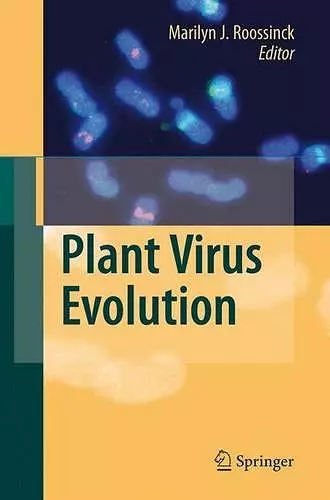

Plant Virus Evolution
Format:Paperback
Publisher:Springer-Verlag Berlin and Heidelberg GmbH & Co. KG
Published:19th Oct '10
Should be back in stock very soon
The evolution of viruses has been a topic of intense investigation and theoretical development over the past several decades. Numerous workshops, review articles, and books have been devoted to the subject. Medical practitioners have recognized the importance of viral evolution when treating patients with viral diseases. Farmers have recognized the importance of understanding virus evolution in combating emerging viral diseases in their crop plants. As with any field where knowledge is rapidly expanding, many controversies have also arisen about the nature of virus evolution, how to describe virus populations, how to analyze sequence data and estimate phylogenies, etc. Differing points of view will also be found in the various chapters of this book, and I leave it to the readers to decide for themselves which side they find most helpful. In some cases it seems to me that all sides are correct. In other cases, future historians will decide. This book focuses on the evolution of plant viruses, although some chapters also draw on the more extensive knowledge of animal viruses. It covers topics on evo- tionary mechanisms, viral ecology and emergence, appropriate methods for analysis, and the role of evolution in taxonomy. It includes RNA viruses, DNA viruses, integrated viruses and viroids.
ISBN: 9783642094897
Dimensions: unknown
Weight: unknown
224 pages
1st ed. Softcover of orig. ed. 2008